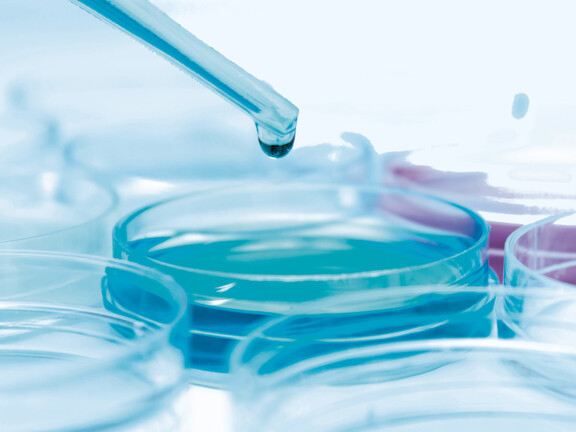

Eine Miete – alles inklusive
Die Full-Service-Wartung für die Wasseraufbereitung der Direkt-Raumluftbefeuchtung mit Hochdruck-Luftbefeuchtern garantiert maximale Betriebssicherheit, 100% Hygiene und Wirtschaftlichkeit.
Um nichts kümmern
Die Luftbefeuchtung ist durch die präventive Wartung immer absolut betriebssicher und hygiensich.
Immer auf dem neuesten Stand
Technische Neuerungen und Aktualisierungen werden automatisch und kostenlos installiert.
Lebenslange Garantie
Kostenfrei werden während der Mietdauer alle Verschleiß- und Ersatzteile der Systeme ersetzt.

Luftbefeuchtung zum Entspannen
Die Sicherheit und Hygiene einer Luftbefeuchtungsanlage hängt maßgeblich von einem durchdachten und konsequent umgesetzten Wartungskonzept ab. Um die Wartung der Direkt-Raumluftbefeuchtung mit Hochdruck-Luftbefeuchtern so einfach und bequem wie möglich zu machen, stehen Wasseraufbereitungsysteme in austauschbaren Kleincontainern zur Verfügung. Im Rahmen einer Full-Service-Miete erhalten die Kunden dieser Condair Systeme alle sechs Monate komplett gewartete und desinfizierte Austauschcontainer zugeschickt. Alle Kosten für Hygienekontrollen, Desinfektionen, Ersatzteile oder Störfälle sind in diesem Full-Service-Paket inklusive. Zusätzlich werden technische Neuerungen und Updates automatisch nachgerüstet, so dass diese Luftbefeuchtungsanlagen immer mitwachsen und nie alt werden.
Höchste Sicherheit und Hygiene
Die Full-Service-Miete gewährleistet, dass alle Module der für die Luftbefeuchtung benötigten Wasseraufbereitung halbjährlich automatisch ausgetauscht und zur professionellen Wartung an Condair zurückgesendet werden. Dadurch müssen sich Anwender nicht eigenständig um Hygienemaßnahmen kümmern und können sicher sein, dass beispielsweise Keimobergrenzen jederzeit eingehalten werden. Die Einhaltung aller relevanten Arbeitsschutz- und Hygienevorschriften wird durch den regelmäßigen Austausch und die professionelle Wartung der Kleincontainer sichergestellt und dokumentiert. Nationale und internationale Zertifikate unabhängiger Prüfstellen bestätigen den hohen Hygienestandard dieser Systeme und der umfassenden Wartungskonzepte.

Full-Service im Mietpaket
Alle sechs Monate wird jedes System der Wasseraufbereitung und Hochdruckpulsation getauscht: Jede Anlage wird bei Condair komplett demontiert. Alle Einzelteile werden geprüft und gereinigt. Verschleißteile werden erneuert. Spezielle Spülungen reinigen und desinfizieren die Systeme. Auf Spezialprüfständen justieren speziell geschulte Techniker die Systeme exakt auf das individuelle Leistungsprofil ein. Im Labor werden Wasserproben auf Gesamtkeimzahl geprüft. Nach Abschluss aller Arbeiten werden die Wartungen dokumentiert und die Anlagen transportsicher verpackt und an die Kunden versendet. Mit wenigen Handgriffen ist das benutzte System gegen einen rundum gewarteten Container ausgetauscht. Schnellkupplungen verbinden die Container einfach und schnell wieder mit dem Rohrsystem.


Containeraustausch
Versand an den Kunden
Spezielle Prüfstände
Komplettservice-Wartung
Reinigung und Desinfektion

Infopaket Direkt-Raumluftbefeuchtung
Passt immer - hier informieren!Direkt-Raumluftbefeuchter werden gezielt dort eingesetzt, wo die Luftfeuchte benötigt wird. Für jede Anwendung und Raumgröße, ideal zur Nachrüstung, energieeffizient und wartungsfreundlich.
Hier kostenloses Infopaket anfordern und gratis Thermo-Hygrometer zur Messung Ihrer Luftfeuchte sichern!
Welche Vorteile hat eine Full‑Service‑Wartung der Luftbefeuchtungsanlage?
Wie funktioniert die Full‑Service‑Wartung im Mietpaket?
Welche Vorteile bietet die Full‑Service‑Miete gegenüber einer Vor‑Ort‑Wartung?
In welchem Intervall findet die Full-Service-Wartung statt?
Wie schützt die Full‑Service‑Miete vor Haftungsrisiken?
Kontaktieren Sie uns
Wir freuen uns auf Ihre Nachricht und Ihre Wünsche zur Direkt-Raumluftbefeuchtung für Ihre Anwendung.
Hier erhalten Sie weitere Informationen oder eine persönlichen Beratung.
Mehr Informationen oder Fragen?
Hier geht es zu unseren Kontaktformular Condair Direkt-Raumluftbefeuchtung
Direkter Kontakt zu Ihrem Berater
Hier finden Sie den Berater für Ihre Region zur Condair Direkt-Raumluftbefeuchtung









